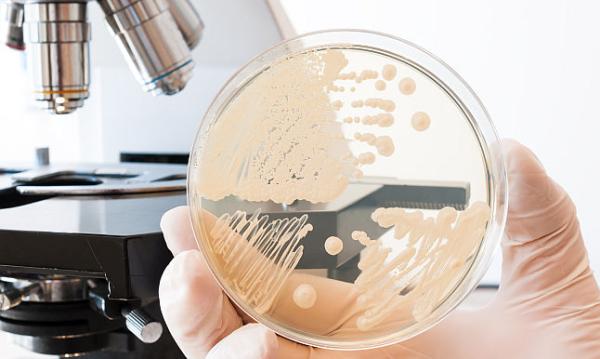
Cum se trateaza corect candidoza si de ce reapare?

Cum se trateaza corect candidoza si de ce reapare?

Dr. Cora Balaban-Popa
Medic specialist neonatolog
Clinica: Spitalul Municipal Campina
Ce este candidoza
Candidoza este o infectie fungica comuna cel mai frecvent cauzata de Candida albicans. Alte specii care pot provoca infectii sunt Candida tropicalis, Candida glabrata, Candida parapsilosis sau Candida krusei, dar acestea sunt mult mai rar intalnite. Candida traieste in mod normal pe piele si in interiorul corpului, in locuri precum gura, gat, intestin si vagin, fara a crea probleme.
Cauze
De obicei, Candida este tinuta sub control de flora comensala (totalitatea bacteriilor care traiesc in organismul unei persoane sanatoase si care nu determina boala) si de apararea imuna a organismului. In cazul administrarii de antibiotice sau alte substante care modifica ph-ul zonelor in care traiesc aceste bacterii, flora este afectata si nu mai poate apara organismul de Candida, ceea ce ii permite acesteia sa se multiplice si sa provoace simptome.
Un alt motiv pentru aparitia acestei infectii este sistemul imunitar slabit. Persoanele cu SIDA sau alte boli care au un impact negativ asupra sistemului imun, se confrunta cu infectii mai grave si mai greu de tratat. In cazul acestor pacienti, candidoza poate pune viata in pericol daca trece in sange si se raspandeste in organele vitale.
Tipuri de infectii cu Candida
Stomatita candidozica
Aceasta infectie este localizata la nivelul cavitatii bucale, in special pe limba, interiorul obrajilor si palat, si se caracterizeaza prin aparitia unor leziuni si acumularea unor depozite albicioase, dureroase.
Daca se incearca indepartarea acestor suprafete se gaseste de obicei o zona rosie, inflamata, care poate sangera usor. Printre alte simptome se numara si pierderea gustului, durere in timpul masticatiei sau la inghitire si crapaturi si roseata la colturile gurii.
Esofagita candidozica
Infectiile cu candida ale cavitatii orale se pot raspandi in zona amigdalelor, in partea din spate a gatului (faringe) sau chiar pot cobori pana in esofag, provocand esofagita.
Infectia ajunsa la acest nivel poate face si mai dificil actul de a inghiti, cauzand o durere localizata in piept, retrosternal (in spatele sternului), putand provoca de asemenea greata si varsaturi.
Candidoza cutanata
Candida poate provoca eruptii cutanate in zonele unde pielea este neobisnuit de umeda, de exemplu zona scutecului sau mainile oamenilor care poarta in mod obisnuit manusi de cauciuc. Candidoza cutanata provoaca leziuni la nivelul pielii, inflamatie si eritem, mancarime intensa si chiar infectia foliculului de par.
Articole recomandate
-
 Candidoza orala sau stomatita candidozica
Candidoza orala sau stomatita candidozica
-
 Candidoza vaginala
Candidoza vaginala
-
 Diferentele dintre candidoza vaginala si cea bucala - cauze, simptome si tra ...
Diferentele dintre candidoza vaginala si cea bucala - cauze, simptome si tra ...
-
 Ce influenteaza echilibrul natural al organismului si cum il mentinem
Ce influenteaza echilibrul natural al organismului si cum il mentinem
-
 Poate un sampon sa previna caderea parului?
Poate un sampon sa previna caderea parului?
-
 Cum puteti recunoaste candidoza cutanata si cum se poate trata?
Cum puteti recunoaste candidoza cutanata si cum se poate trata?
-
 Cum se trateaza corect candidoza
Cum se trateaza corect candidoza
-
 Candidoza cutanata
Candidoza cutanata
Candidoza vaginala
Infectiile mucoasei vaginale nu sunt de obicei transmise sexual. Pe parcursul unei vieti, 75% dintre toate femeile sunt susceptibile de a avea cel putin o infectie vaginala cu Candida si pana la 45% au 2 sau mai multe.
Infectiile cauzate de Candida la nivelul mucoasei vaginale pot provoca mancarime si sau durere, o secretie vaginala densa, cu o textura ca branza moale sau de vaci, cu un miros intepator, durere in timpul actului sexual si durere sau disconfort la urinare. Desi de cele mai multe ori infectia din zona vaginala se manifesta prin simptome usoare sau moderate, unele femei pot dezvolta infectii severe care implica roseata, umflaturi si fisuri in peretele vaginului.
Candidoza profunda - sepsis
In candidoza profunda, Candida contamineaza fluxul sanguin si se raspandesc in tot corpul, provocand infectii severe. Cand Candida se raspandeste in sange, aceasta poate provoca o gama larga de simptome, de la febra inexplicabila la soc si insuficienta multipla de organe.
Diagnostic
Daca ajungi la specialist cu o infectie cauzata de Candida, acesta va solicita detalii despre istoricul personal medical, despre rutina zilnica de ingrijire a pielii, dieta urmata sau despre posibile tratamente cu antibiotice sau medicamente care pot suprima sistemul imunitar.
Adesea, medicul poate diagnostica stomatita candidozica, candidoza cutanata sau infectia vaginala cu Candida printr-un simplu examen fizic. Cu toate acestea, in cazul in care diagnosticul este incert, medicul poate recolta o proba prin razuirea usoara a suprafetei implicate pentru examinare la microscop sau il poate trimite pentru cultura. O cultura este utila mai ales daca pacientul se confrunta cu o infectie care nu cedeaza cu tratament uzual sau revine dupa tratament la scurt timp.
Pentru a diagnostica candidoza esofagiana este nevoie de un medic specialist care va examina esofagul cu ajutorul unui endoscop, un instrument flexibil care este introdus in gat si care permite vizualizarea zonei afectate. In timpul acestei examinari, numita endoscopie, medicul va prelua un esantion de tesut (fie o biopsie, fie o „periere”) din esofag pentru a fi examinat intr-un laborator.
Pentru a diagnostica candidoza profunda, medicul va recolta o proba de sange pentru a fi analizata intr-un laborator in vederea identificarii agentului infectios.
Tratament
In cazul infectiilor cu Candida, medicatia de electie este reprezentata de tratamentul cu antifungice. Majoritatea candidozelor trec dupa administrarea de fluconazol, insa pot fi necesare alte tratamente pentru infectiile mai severe, care nu cedeaza usor sau care revin dupa ce se remarca o aparenta ameliorare.
In functie de zona afectata putem utiliza diferite preparate antifungice.
Candidoza bucala
Medicii trateaza formele usoare cu medicamente antifungice topice.
Candidoza esofagiana
Se prefera utilizarea unui antifungic oral.
Candidoza cutanata
Aceasta infectie a pielii poate fi tratata eficient cu o varietate de pulberi si creme antifungice. Zona afectata trebuie mentinuta curata, uscata si protejata de frecare.
Candidoza vaginala
Infectiile vaginale pot fi tratate cu antifungice care se aplica direct in vagin sub forma de creme, unguente sau ovule.
De obicei, partenerii sexuali nu trebuie sa fie tratati. Cu toate acestea se recomanda evitarea contactului sexual pe durata infectiei.
Candidoza profunda
Tratamentul acestei infectii incepe de obicei cu un medicament antifungic intravenos. Persoanele cu un numar foarte mic de celule albe in sange pot avea nevoie de un medicament antifungic intravenos alternativ.
Prognostic
De obicei, la persoanele fara patologii preexistente care se confrunta cu forme usoare de candidoza, o infectie tratata corespunzator dispare fara a lasa daune permanente.
La persoanele cu boli cronice sau sistem imunitar slabit, episoadele de candidoza pot fi mai rezistente la tratament si pot reveni dupa terminarea tratamentului. In cazul unei candidoze profunde, cei care sunt diagnosticati rapid si tratati eficient au cel mai bun prognostic, mai ales daca infectia poate fi oprita inainte ca aceasta sa se raspandeasca in organele vitale.
De ce reapare?
Infectiile recurente reapar datorita dezechilibrelor frecvente ale bacteriilor benefice din diferite zone ale corpului. Candida tinde, de asemenea, sa prospere in conditii umede, cum ar fi transpiratia sau saliva. Lipsa unor practici de igiena regulate, cum ar fi dusurile zilnice si spalarea dintilor poate duce, de asemenea, la infectii recurente. De asemenea, persoanele cu sistem imun deficitar sunt predispuse la reinfectie.
Alte motive pentru care candidoza poate sa reapara sunt: infectia initiala nu a fost tratata complet, tulpina de Candida este rezistenta la tratamentul administrat sau chiar este posibil sa nu fie vorba despre o infectie fungica, ci o alta de natura diferita care sa mimeze doar simptomele.
Concluzii
Candidoza este printre cele mai frecvente si raspandite infectii fungice. Desi in majoritatea cazurilor nu este o afectiune care sa puna viata in pericol, aceasta infectie iti poate perturba stilul de viata intr-o oarecare masura. Cu ajutorul unui comportament preventiv si ascultand de sfaturile medicului, putem tine departe orice tip de candidoza si sa o tratam corect in situatia in care ea apare.
Ai o propunere de completare sau neclarități?
In cazul in care articolul nu a acoperit in totalitate un anumit aspect care va intereseaza, va incurajam sa ne trimiteti sugestii pentru completare. Astfel, ne veti ajuta sa completam si sa imbunatatim continutul pentru toti cititorii.
Articole recomandate
-
 Candidoza bucala - cauze, simptome si tratament
Candidoza bucala - cauze, simptome si tratament
-
 Candidoza esofagiana
Candidoza esofagiana
-
 Candidoza orala - diagnostic si tratament
Candidoza orala - diagnostic si tratament
-
 Candidoza sistemica
Candidoza sistemica
-
 Candidoza vaginala – simptome si diagnostic
Candidoza vaginala – simptome si diagnostic
-
 Cum sa slabesti fara sa pierzi masa musculara. Rolul dietelor VLCD si adevar ...
Cum sa slabesti fara sa pierzi masa musculara. Rolul dietelor VLCD si adevar ...
-
 Tratament candidoza vaginala
Tratament candidoza vaginala
-
 Candidoza orala – cauze si simptome
Candidoza orala – cauze si simptome


 Candidoza orala sau stomatita candidozica
Candidoza orala sau stomatita candidozica
 Candidoza vaginala
Candidoza vaginala
 Diferentele dintre candidoza vaginala si cea bucala - cauze, simptome si tra ...
Diferentele dintre candidoza vaginala si cea bucala - cauze, simptome si tra ...
 Ce influenteaza echilibrul natural al organismului si cum il mentinem
Ce influenteaza echilibrul natural al organismului si cum il mentinem Poate un sampon sa previna caderea parului?
Poate un sampon sa previna caderea parului? Cum puteti recunoaste candidoza cutanata si cum se poate trata?
Cum puteti recunoaste candidoza cutanata si cum se poate trata?
 Cum se trateaza corect candidoza
Cum se trateaza corect candidoza
 Candidoza cutanata
Candidoza cutanata
 Candidoza bucala - cauze, simptome si tratament
Candidoza bucala - cauze, simptome si tratament
 Candidoza esofagiana
Candidoza esofagiana
 Candidoza orala - diagnostic si tratament
Candidoza orala - diagnostic si tratament
 Candidoza sistemica
Candidoza sistemica
 Candidoza vaginala – simptome si diagnostic
Candidoza vaginala – simptome si diagnostic
 Cum sa slabesti fara sa pierzi masa musculara. Rolul dietelor VLCD si adevar ...
Cum sa slabesti fara sa pierzi masa musculara. Rolul dietelor VLCD si adevar ... Tratament candidoza vaginala
Tratament candidoza vaginala
 Candidoza orala – cauze si simptome
Candidoza orala – cauze si simptome